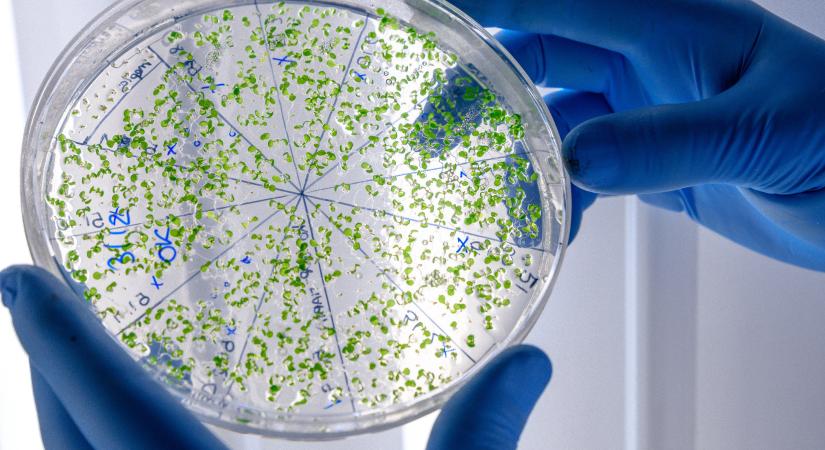

Magyarország egyénre szabott koktélterápiával készül a gyilkos szuperbaktérium-járványra
Az antibiotikumok kora lejáróban van, a Debreceni Egyetem kutatói szerint a jövő a bakteriofágoké, amelyek egyénre szabottan, akár szennyvízből tenyésztve segíthetnek legyőzni a multirezisztens kórokozókat, a szuperbaktériumokat.
Hamarosan átirányítunk a teljes cikkhez → 168.hu